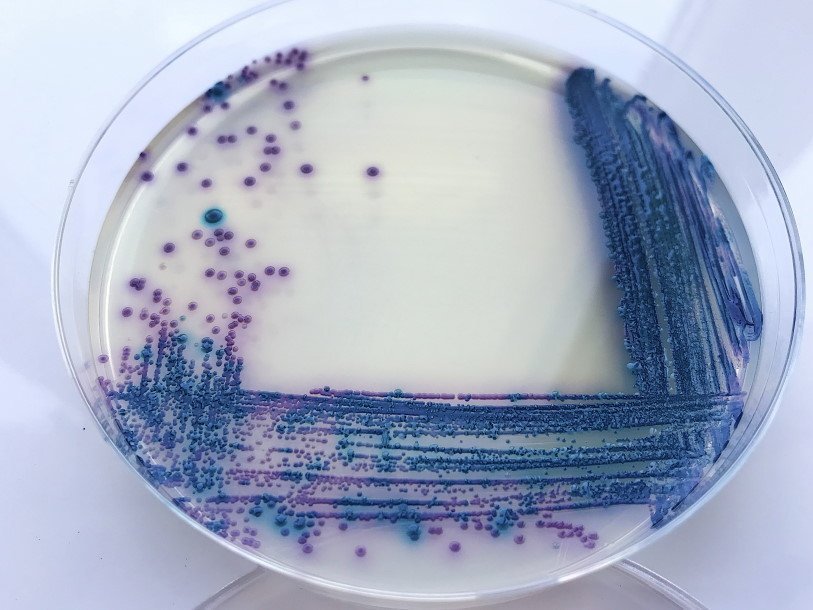

Екатерина Беленко: Промикробы: Моча, окутанная мифами
Культуры Escherichia coli и Klebsiella pneumoniae на посеве мочи пациента Екатерина Беленко
Культуры Escherichia coli и Klebsiella pneumoniae на посеве мочи пациента Екатерина Беленко Долгое время врачи были убеждены, что моча в норме стерильна, а значит, любого микроба, появившегося в ней, надо незамедлительно выгнать поганой метлой. А ещё это породило странный миф, что мочу можно пить или поливать ею ожог. Не, ну можно, конечно, кто ж вам запретит? Но не нужно, лучше промойте место ожога и охладите его.
Не только моча вселяла веру в нетронутость микробами, на протяжении многих лет органы дыхания, матка, плацента и другие части организма считались зоной, свободной от микробов. Думаю, что вы уже догадались, к чему я веду. Да-да, современные данные опровергают эту стерильную теорию.
Давным-давно пора свыкнуться с тем, что это мы живём на их планете, а не наоборот. И действительно было очень наивно полагать, что вот во влагалище в норме микробы живут и активно тусуются, а в матку они ни-ни, запрещено. Микробы — невыводимая невидимая часть наших организмов и мира вокруг нас, смиритесь. И бактерии — это не только источники инфекций и фу какая гадость, но и наши друзья и помощники и вообще отличные ребята. Абсурдно было думать, что здоровые мочевые пути абсолютно не содержат внутри себя бактерий, учитывая, в каком изобилии те растут по всему организму.
Но если уж и симптомы неприятные есть, и в посеве мочи кто-то обнаружился, тогда надо от незваных гостей избавляться. Они, эти гости, как самые настоящие гопники, иногда ходят парами. Вот как на фото — дуэт из Escherichia coli и Klebsiella pneumoniae. Эта чашка Петри, которую вы видите, — не первичный посев мочи, а уже попытка разрушить их прочный союз, чтобы с каждой культурой по отдельности дальше работать. Два микроба — значит, две постановки антибиотикочувствительности. Если повезёт, то в них найдутся пересечения, то есть один антибиотик будет убивать сразу обоих. За двумя зайцами, но с большим успехом, чем в пословице. Ну, а если не повезёт, то пациенту предстоит курс из двух антимикробных препаратов. Но главное, чтобы их назначал врач, а не Интернет, хотя вы это и сами понимаете, я надеюсь.
И, пользуясь случаем, хочу открыть вам секрет: для посева мочи достаточно объёма столовой ложки, не надо под самую крышечку наливать. А самое-самое главное — эту крышечку закручивайте поплотнее, пожалуйста.
Смотрите также: Екатерина Беленко Промикробы: Загадочный дисбактериоз Екатерина Беленко Промикробы: Знакомьтесь, синегнойная палочка! Екатерина Беленко Среда для микробиологов Екатерина Беленко Микробы, они везде